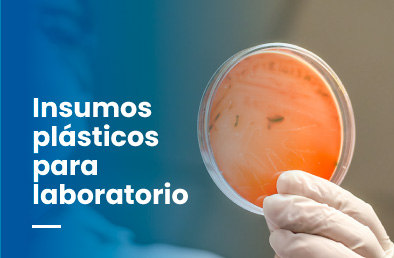
LTech

Productos Destacados
G42190100
Matraz aforado con tapa, clase a, 100mL
MATRAS AFORADO CON TAPA PLASTICA, ESMERILADO 12/14... See more
AMP1710
Corazon y traquea distal, carina y bronquios primarios
Corazon y traquea distal, carina y bronquios primarios... See more